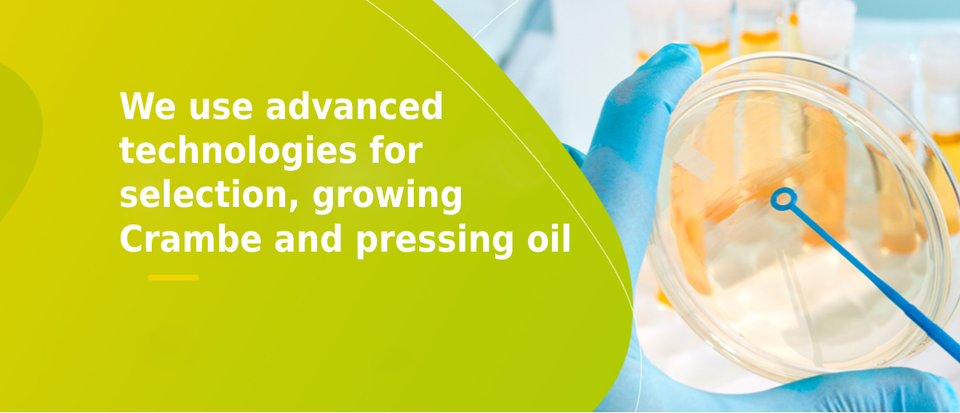

SANS MOTS Marque D'OR กับไฟโตสเตอรอล,คลอโรฟิลล์,Phospholipids และ Retinoids น้ำมันฟื้นฟูผิว
ยังไม่มีรีวิว

คุณลักษณะ
Phytoconcentrate Oil SANS MOTS Marque D'ORหมายเลขรุ่น
Crambis LLCชื่อแบรนด์
Republic of Bashkortostan, Russian Federationสถานที่กำเนิด
30 mlปริมาณ
คุณสมบัติที่สำคัญ
หมายเลขรุ่น
Phytoconcentrate Oil SANS MOTS Marque D'OR
ชื่อแบรนด์
Crambis LLC
สถานที่กำเนิด
Republic of Bashkortostan, Russian Federation
ปริมาณ
30 ml
บรรจุภัณฑ์และการนำส่ง
Packaging Details
Box
Port of dispatch
Ufa
ขายหน่วย
รายการเดียว
ความสามารถในการจัดส่ง
Supply Ability
14000 ชิ้น ต่อ Week
ระยะเวลารอสินค้า
ตัวเลือกการปรับแต่ง
By request (ยอดซื้อขั้นต่ำ : 1,400 ชิ้น )
ดูรายละเอียด
คำอธิบายผลิตภัณฑ์จากซัพพลายเออร์
คำเตือน/ข้อสงวนสิทธิ์
แคลิฟอร์เนียเสนอ65เตือนผู้บริโภคดูเพิ่มเติม
ปรับแต่งได้
จำนวนสั่งซื้อขั้นต่ำ : 1 ชิ้น
฿2,679.31
รูปแบบ
เลือกเลยสี
ตัวเลือกการปรับแต่ง
By request (สั่งซื้อขั้นต่ำ : 1,400 ชิ้น )
การจัดส่ง
โซลูชันการจัดส่งสำหรับปริมาณที่เลือกไม่มีให้บริการในขณะนี้

SANS MOTS Marque D'OR กับไฟโตสเตอรอล,คลอโรฟิลล์,Phospholipids และ Retinoids น้ำมันฟื้นฟูผิว
